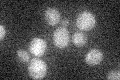
YDR232W
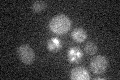
YDR232W

View description
5-aminolevulinate synthase, catalyzes the first step in the heme biosynthetic pathway; an N-terminal signal sequence is required for localization to the mitochondrial matrix; expression is regulated by Hap2p-Hap3p
Localization:
Intensity:
Fold change:
Significance:
-
C’ GFP library in SD
below threshold16.61 -
N' NOP1pr-GFP in SD

mitochondria123.971 -
N' TEF2pr-mCherry in SD

mitochondriaN/A -
N' NATIVEpr-GFP in SD

cytosol,punctate,mitochondria18.6375 -
N' TEF2pr-VC and Cyto-VN in SD

#N/A0 -
C’ GFP library in SD+DTT

cytosol14.890.89No -
C’ GFP library in SD+H2O2

cytosol16.250.97No -
C’ GFP library in Starvation Media
cytosol13.820.83No -
C’ GFP library on the background of Pup2-DaMP

below threshold -
C’ GFP library on the background of CCT mutant

below threshold19.02531.14481No
